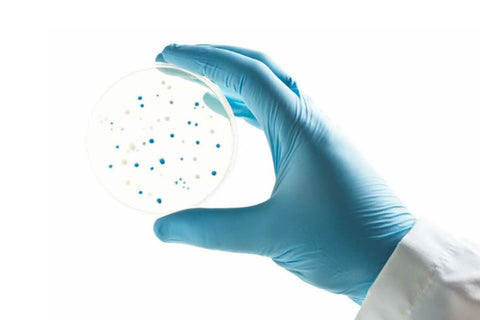

The CellCore Biosciences difference
CellCore supplements are formulated and produced by a team of researchers and scientists to guarantee quality, potency, and purity. With a special focus on developing innovative solutions and creating proprietary blends, including their exclusive Carbon Technology, CellCore has developed a range of products entirely unique in the nutritional supplement industry. With a focus on detoxifying the body and removing pathogens from the gut and intestines, every product contains natural ingredients that are carefully researched, ethically sourced and are free of binders, additives, fillers, artificial ingredients, and chemicals.
Introducing proprietary Carbon Technology
CellCore's proprietary Carbon Technology or 'BioActive Carbons' are a new class of all-in-one-binders that are formulated from a blend of extracts from fulvic and humic acids, and polyelectrolytes. These ingredients work together with the unique ability to recognise, bind onto and eliminate toxins, restore mineral and nutritional support and deliver carbon, hydrogen and oxygen molecules to maintain normal cellular and tissue repair processes. Rediscover root level well-being with the advanced detoxification and nutritional support provided by Carbon Technology.
While TheraStore aims to keep product images & information up to date, changes made by suppliers & manufacturers to packaging or ingredients may not be immediately reflected online. As a result, you may receive items with different packaging. Rest assured, all products are guaranteed fresh & authentic. Always check labels before use, & feel free to contact us with any queries.